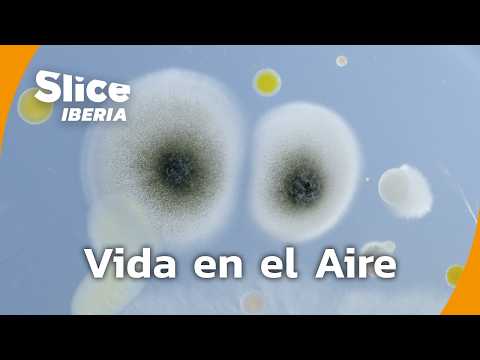
Plankton Aéreo: La Vida Invisible que Respiramos | SLICE Iberia | DOCUMENTAL COMPLETO

About 34 results for "UCvvOHrs5pzdWg_zaFIpO8xQ"
Featured Results

PT25M52S
La Catedral de San Basilio: Símbolo de la Rusia Ortodoxa | SLICE Iberia | DOCUMENTAL COMPLETO
SLICE IberiaNov 19, 2025
PT50M10S
Corea: La Guerra que Nunca Terminó | SLICE Iberia | DOCUMENTAL COMPLETO
SLICE IberiaNov 18, 2025
De Alemania a Sudamérica: La Sombra de los Nazis Fugitivos | SLICE Iberia | DOCUMENTAL COMPLETO
SLICE IberiaOct 19, 2025
La Esfinge y las Pirámides de Kefrén y Micerino en Guiza | SLICE Iberia | DOCUMENTAL COMPLETO
SLICE IberiaOct 18, 2025
PT52M31S
Mujeres bajo el Tercer Reich: entre la utopía y la opresión| SLICE Iberia | DOCUMENTAL COMPLETO
SLICE IberiaSep 18, 2025
PT51M2S
Plankton Aéreo: La Vida Invisible que Respiramos | SLICE Iberia | DOCUMENTAL COMPLETO
SLICE IberiaAug 16, 2025
PT50M22S
Cabras: Compañeras Emocionales e Increíblemente Listas | SLICE Iberia | DOCUMENTAL COMPLETO
SLICE IberiaAug 2, 2025
PT54M45S
Conferencia de Yalta: de la unidad al conflicto | SLICE Iberia | DOCUMENTAL COMPLETO
SLICE IberiaJun 26, 2025
PT51M8S
Adiestrar águilas reales: Arte ancestral de los nómadas kazajos | SLICE Iberia | DOCUMENTAL COMPLETO
SLICE IberiaJun 24, 2025
El cielo podría caer: cómo la ciencia busca desviar asteroides | SLICE Iberia | DOCUMENTAL COMPLETO
SLICE IberiaJun 19, 2025
PT2H46M55S
MEGA EPISODIO: Historia, fuego y gloria: Notre-Dame, la Torre Eiffel y Mónaco | SLICE Iberia
SLICE IberiaMay 18, 2025
PT49M15S
El cangrejo gigante que amenaza el Ártico | SLICE Iberia | DOCUMENTAL COMPLETO
SLICE IberiaMar 19, 2025
PT5H20M44S
MEGA EPISODIO: Egipto: Misterios y Tesoros de Tutankamón a Cleopatra | SLICE Iberia
SLICE IberiaFeb 22, 2025
PT52M10S
La pirámide perdida de Sekhemkhet | SLICE Iberia | DOCUMENTAL COMPLETO
SLICE IberiaDec 21, 2024
PT50M9S
Asedio de Orleans: La defensa de la ciudad y su liberación | SLICE Iberia | DOCUMENTAL COMPLETO
SLICE IberiaDec 19, 2024
PT49M11S
La Búsqueda de las Reliquias de Cristo: Historia y Fe | SLICE Iberia | DOCUMENTAL COMPLETO
SLICE IberiaDec 19, 2024
PT52M18S
Tormentas de arena en Beijing: China contra los desiertos | SLICE Iberia | DOCUMENTAL COMPLETO
SLICE IberiaDec 19, 2024
PT49M31S
El Cristianismo y sus Grandes Monumentos: Un Viaje en el Tiempo | SLICE Iberia | DOCUMENTAL COMPLETO
SLICE IberiaDec 18, 2024
PT49M51S
El misterio de la mano momificada de Cleopatra | SLICE Iberia | DOCUMENTAL COMPLETO
SLICE IberiaDec 17, 2024
Los misterios de la pirámide de Pepi II | SLICE Iberia | DOCUMENTAL COMPLETO
SLICE IberiaDec 17, 2024
PT51M48S
La singularidad arquitectónica de la pirámide de Micerinos | SLICE Iberia | DOCUMENTAL COMPLETO
SLICE IberiaNov 28, 2024
PT46M36S
Pulpo: 9 cerebros, 3 corazones y una inteligencia asombrosa | SLICE Iberia | DOCUMENTAL COMPLETO
SLICE IberiaSep 26, 2024
PT50M16S
1929: Cuando La burbuja especulativa se rompió | SLICE Iberia | DOCUMENTAL COMPLETO
SLICE IberiaJun 29, 2024
PT52M50S
El desafio de la de la construcción de la Torre Eiffel | SLICE Iberia | DOCUMENTAL COMPLETO
SLICE IberiaJun 13, 2024
PT48M27S
La revolución científica de los nuevos telescopios | SLICE Iberia | DOCUMENTAL COMPLETO
SLICE IberiaJun 1, 2024
PT50M57S
El misterio del submarino perdido | SLICE Iberia | DOCUMENTAL COMPLETO
SLICE IberiaMay 4, 2024
PT50M18S






